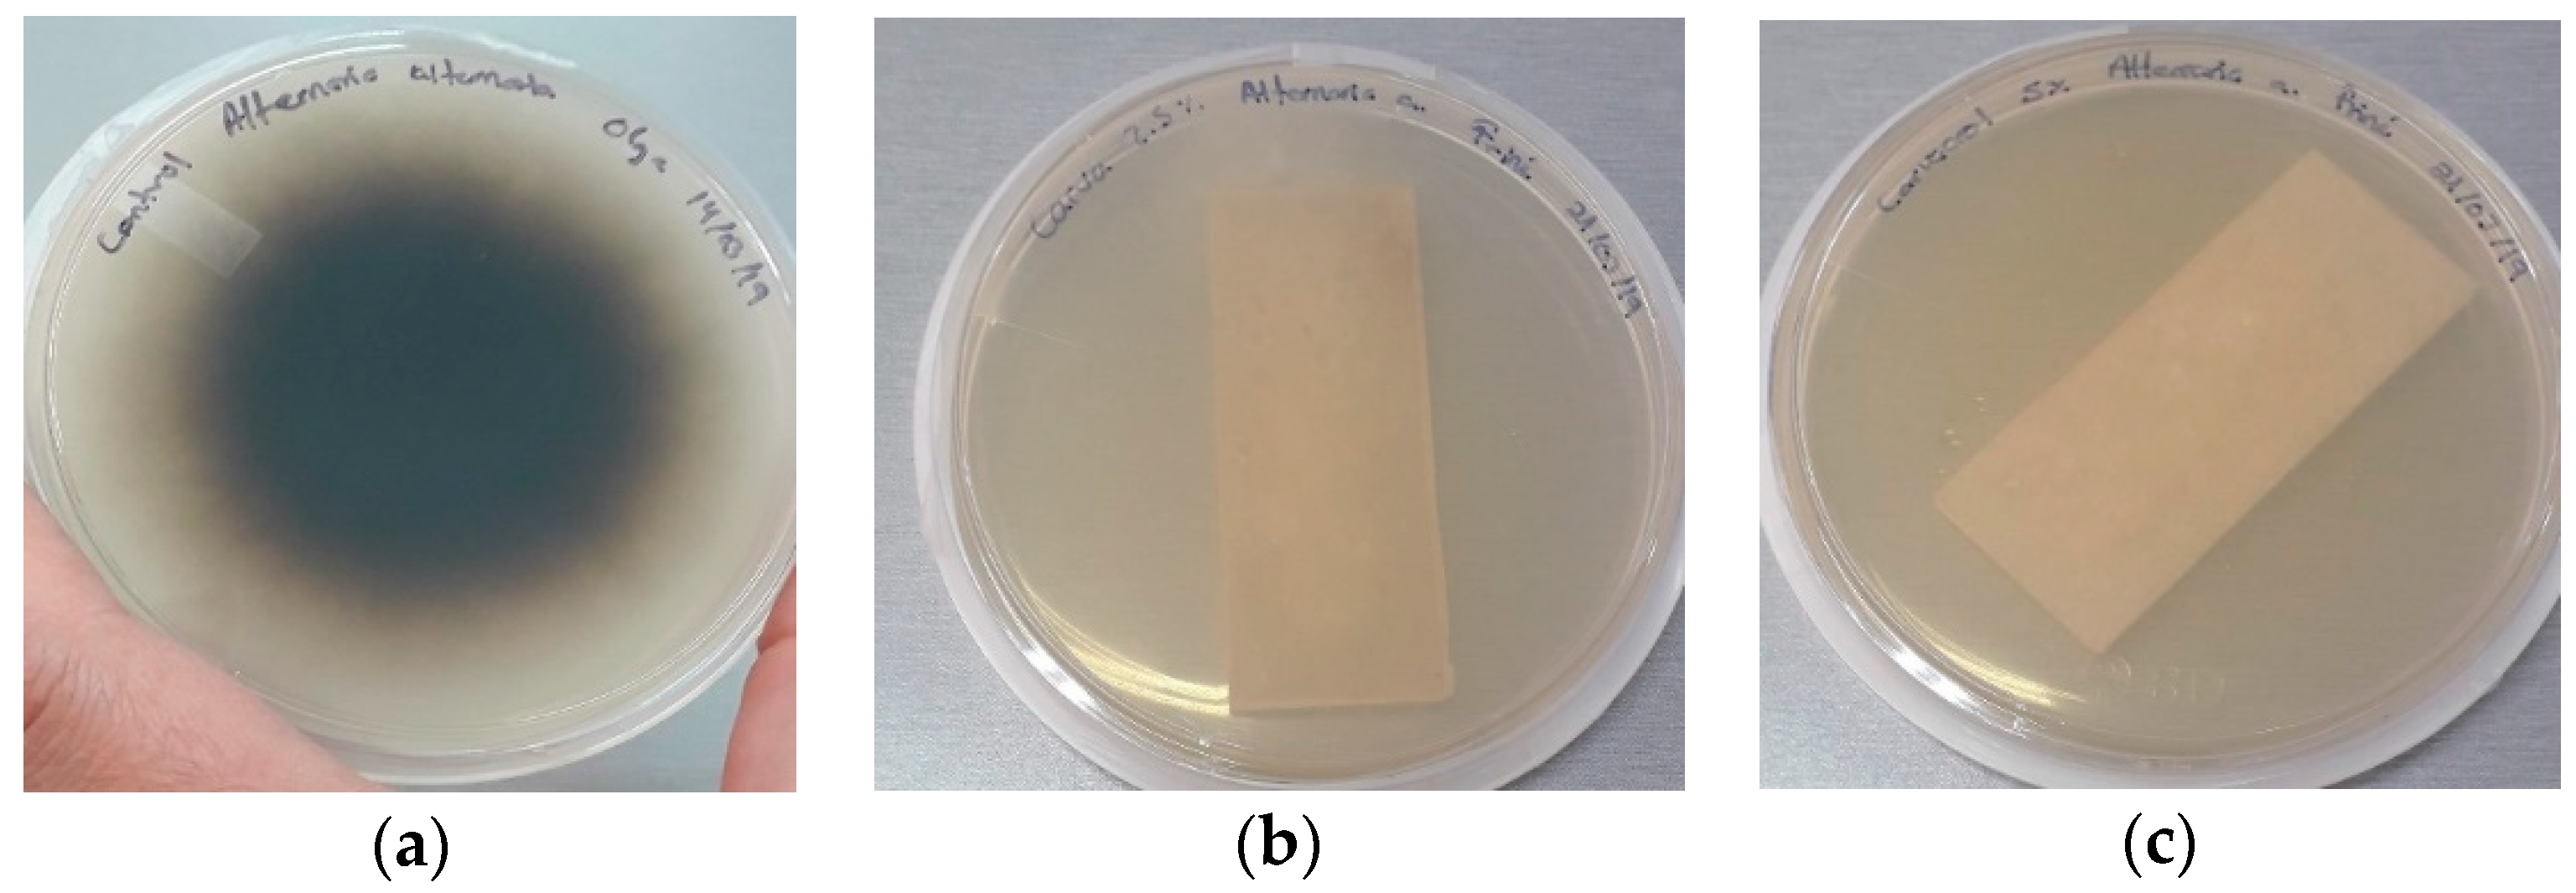
Polymers 11 01720 g007

Development and Characterization of a Biodegradable PLA Food Packaging Hold Monoterpene–Cyclodextrin Complexes against Alternaria alternata
Abstract
:1. Introduction
2. Materials and Methods
2.1. Materials
2.2. Preparation of β-CD Inclusion Complexes
2.3. Atomization Process to Obtain Complexes in Solid State
2.4. Fourier-Transform Infrared Spectroscopy (FTIR)
2.5. Boxes Production
2.6. Packaging Characterization
2.6.1. Mechanical Properties
2.6.2. Scanning Electron Microscopy (SEM)
2.6.3. Thermal Characterization of the Developed Packaging
2.7. Antimicrobial Activity
2.8. Statistical Analysis
3. Results and Discussion
3.1. Assessment of the Obtained Complexes
3.2. Mechanical Properties of PLA Packaging Loaded with β-CD–Carvacrol or β-CD–Thymol Inclusion Complexes
3.3. Scanning Electron Microscopy
3.4. Differential Scanning Calorimetry
3.5. Thermogravimetry (TGA)
3.6. Antifungal Assays
4. Conclusions
Author Contributions
Funding
Conflicts of Interest
References
- Francis, G.A.; Gallone, A.; Nychas, G.J.; Sofos, J.N.; Colelli, G.; Amodio, M.L.; Spagno, G. Factors affecting quality and safety of fresh-cut produce. Crit. Rev. Food Sci. Nutr. 2012, 52, 595–610. [Google Scholar] [CrossRef] [PubMed]
- De Oliveira, M.A.; De Souza, V.M.; Bergamini, A.M.; De Martinis, E.C. Microbiological quality of ready-to-eat minimally processed vegetables consumed in Brazil. Food Control 2011, 22, 1400–1403. [Google Scholar] [CrossRef]
- Abadias, M.; Usall, J.; Anguera, M.; Solsona, C.; Viñas, I. Microbiological quality of fresh, minimally-processed fruit and vegetables, and sprouts from retail establishments. Int. J. Food Microbiol. 2008, 123, 121–129. [Google Scholar] [CrossRef] [PubMed]
- França, K.R.S.; Silva, T.L.; Cardoso, T.A.L.; Ugulino, A.L.N.; Rodrigues, A.P.M.; De Mendonça Júnior, A.F. In vitro Effect of Essential Oil of Peppermint (Mentha x piperita L.) on the Mycelial Growth of Alternaria alternata. J. Exp. Agric. 2018, 26, 1–7. [Google Scholar] [CrossRef]
- Muller, J.; González-Martínez, C.; Chiralt, A. Combination of poly (lactic) acid and starch for biodegradable food packaging. Materials 2017, 10, 952. [Google Scholar] [CrossRef] [PubMed]
- Murariu, M.; Dubois, P. PLA composites: From production to properties. Adv. Drug Deliv. Rev. 2016, 107, 17–46. [Google Scholar] [CrossRef] [PubMed]
- Zhou, L.; Zhao, G.; Jiang, W. Mechanical properties of biodegradable polylactide/poly (ether-block-amide)/thermoplastic starch blends: Effect of the crosslinking of starch. J. Appl. Polym. Sci. 2016, 133, 7. [Google Scholar] [CrossRef]
- Qi, X.; Ren, Y.; Wang, X. New advances in the biodegradation of Poly(lactic) acid. Int. Biodeterior. Biodegrad. 2017, 117, 215–223. [Google Scholar] [CrossRef]
- Huang, T.; Qian, Y.; Wei, J.; Zhou, C. Polymeric antimicrobial food packaging and its applications. Polymers 2019, 11, 560. [Google Scholar] [CrossRef]
- Ahmed, J.; Hiremath, N.; Jacob, H. Antimicrobial, rheological, and thermal properties of plasticized polylactide films incorporated with essential oils to inhibit Staphylococcus aureus and Campylobacter jejuni. J. Food Sci. 2016, 81, 419–429. [Google Scholar] [CrossRef]
- Suriyatem, R.; Auras, R.; Rachtanapun, C.; Rachtanapun, P. Biodegradable rice Strach/carboxymethyl chitosan films with added propolis extract for potential use as active food packaging. Polymers 2018, 10, 954. [Google Scholar] [CrossRef] [PubMed]
- Ribeiro-Santos, R.; Andrade, M.; de Melo, N.R.; Sanches-Silva, A. Use of essential oils in active food packaging: Recent advances and future trends. Trends Food Sci. Technol. 2017, 61, 132–140. [Google Scholar] [CrossRef]
- Wang, L.H.; Zhang, Z.H.; Zeng, X.A.; Gong, D.M.; Wang, M.S. Combination of microbiological, spectroscopic and molecular docking techniques to study the antibacterial mechanism of thymol against Staphylococcus aureus: Membrane damage and genomic DNA binding. Anal. Bioanal. Chem. 2017, 409, 1615–1625. [Google Scholar] [CrossRef] [PubMed]
- Ramos, M.; Jiménez, A.; Garrigós, M.C. Carvacrol-Based Films: Usage and Potential in Antimicrobial Packaging. In Antimicrobial Food Packaging; Academic Press: Cambridge, MA, USA, 2016; pp. 329–338. [Google Scholar] [CrossRef]
- Raybaudi-Massilia, R.M.; Mosqueda-Melgar, J.; Soliva-Fortuny, R.; Martín-Belloso, O. Control of pathogenic and spoilage microorganisms in fresh-cut fruits and fruit juices by traditional and alternative natural antimicrobials. Compr. Rev. Food Sci. Food Saf. 2009, 8, 157–180. [Google Scholar] [CrossRef]
- Saad, N.Y.; Muller, C.D.; Lobstein, A. Major bioactivities and mechanism of action of essential oils and their components. Flavour Fragr. J. 2013, 28, 269–279. [Google Scholar] [CrossRef]
- Ayala-Zavala, J.F.; Soto-Valdez, H.; Gonzalez-Leon, A.; Alvarez-Parrilla, E.; Martin-Belloso, O.; Gonzalez-Aguilar, G.A. Microencapsulation of cinnamon leaf (Cinnamomum zeylanicum) and garlic (Allium sativum) oils in beta-cyclodextrin. J. Incl. Phenom. Macrocycl. Chem. 2008, 60, 359–368. [Google Scholar] [CrossRef]
- Rodríguez-López, M.I.; Mercader-Ros, M.T.; López-Miranda, S.; Pellicer, J.A.; Pérez-Garrido, A.; Pérez-Sánchez, H.; Gabaldón, J.A. Thorough characterization and stability of HP-β-cyclodextrin thymol inclusion complexes prepared by–microwave technology: A required approach to a successful application in food industry. J. Sci. Food Agric. 2019, 99, 1322–1333. [Google Scholar] [CrossRef]
- Rodríguez-López, M.I.; Mercader-Ros, M.T.; Pellicer, J.A.; Gómez-López, V.M.; Martínez-Romero, D.; Núñez-Delicado, E.; Gabaldón, J.A. Evaluation of monoterpene-cyclodextrin complexes as bacterial growth effective hurdles. Food Control 2020, 108, 106814. [Google Scholar] [CrossRef]
- Serna-Escolano, V.; Serrano, M.; Valero, D.; Rodríguez-López, M.I.; Gabaldón, J.A.; Castillo, S.; Guillén, F.; Zapata, P.J.; Martínez-Romero, D. Effect of Thymol and Carvacrol Encapsulated in Hp-Β-Cyclodextrin by Two Inclusion Methods against Geotrichum citri-aurantii. J. Food Sci. 2019, 84, 1513–1521. [Google Scholar] [CrossRef]
- American Society for Testing and Materials (ASTM). Standard Test Method for Tensile Properties of Plastics; ASTM: West Conshohocken, PA, USA, 2014. [Google Scholar]
- Du, W.X.; Olsen, C.W.; Avena-Bustillos, R.J.; McHugh, T.H.; Levin, C.E.; Mandrell, R.; Friedman, M. Antibacterial effects of allspice, garlic, and oregano essential oils in tomato films determined by overlay and vapour-phase methods. J. Food Sci. 2009, 74, M390–M397. [Google Scholar] [CrossRef]
- Arrieta, M.P.; López, J.; Ferrándiz, S.; Peltzer, M.A. Characterization of PLA-limonene blends for food packaging applications. Polym. Test. 2013, 32, 760–768. [Google Scholar] [CrossRef]
- Ramos, M.; Jiménez, A.; Peltzer, M.; Garrigós, M.C. Characterization and antimicrobial activity studies of polypropylene films with carvacrol and thymol for active packaging. J. Food Eng. 2012, 109, 513–519. [Google Scholar] [CrossRef]
- López-Rubio, A.; Lagaron, J.M. Improvement of UV stability and mechanical properties of biopolyesters through the addition of β-carotene. Polym. Degrad. Stab. 2010, 95, 2162–2168. [Google Scholar] [CrossRef]
- Liu, D.; Li, H.; Jiang, L.; Chuan, Y.; Yuan, M.; Chen, H. Characterization of active packaging films made from poly (lactic acid)/poly (trimethylene carbonate) incorporated with oregano essential oil. Molecules 2016, 21, 695. [Google Scholar] [CrossRef]
- Kumari, A.; Kumar, V.; Yadav, S.K. Plant extract synthesized PLA nanoparticles for controlled and sustained release of quercetin: A green approach. PLoS ONE 2012, 7, e41230. [Google Scholar] [CrossRef]
- Carrasco, F.; Pagés, P.; Gámez-Pérez, J.; Santana, O.O.; Maspoch, M.L. Processing of poly(lactic acid): Characterization of chemical structure, thermal stability and mechanical properties. Polym. Degrad. Stab. 2010, 95, 116–125. [Google Scholar] [CrossRef]
- Hwang, S.W.; Shim, J.K.; Selke, S.E.; Soto-Valdez, H.; Matuana, L.; Rubino, M.; Auras, R. Poly (L-lactic acid) with added α-tocopherol and resveratrol: Optical, physical, thermal and mechanical properties. Polym. Int. 2012, 61, 418–425. [Google Scholar] [CrossRef]
- Llana-Ruiz-Cabello, M.; Pichardo, S.; Bermudez, J.M.; Banos, A.; Nunez, C.; Guillamon, E.; Aucejo, S.; Camean, A.M. Development of PLA films containing oregano essential oil (Origanum vulgare L. virens) intended for use in food packaging. Food Addit. Contam. Part A 2016, 33, 1374–1386. [Google Scholar]
- Laird, K.; Phillips, C. Vapour phase: A potential future use for essential oils as antimicrobials. Lett. Appl. Microbiol. 2012, 54, 169–174. [Google Scholar] [CrossRef]
- Soylu, E.M.; Kurt, S.; Soylu, S. In vitro and in vivo antifungal activities of the essential oils of various plants against tomato grey mould disease agent Botrytis cinerea. Int. J. Food Microbiol. 2010, 143, 183–189. [Google Scholar] [CrossRef]
- Arana-Sánchez, A.; Estarrón-Espinosa, M.; Obledo-Vázquez, E.N.; Padilla-Camberos, E.; Silva-Vázquez, R.; Lugo-Cervantes, E. Antimicrobial and antioxidant activities of Mexican oregano essential oils (Lippia graveolens H. B. K.) with different composition when microencapsulated in beta-ciclodextrin. Lett. Appl. Microbiol. 2010, 50, 585–590. [Google Scholar] [CrossRef] [PubMed]
- Santos, E.H.; Kamimura, J.A.; Hill, L.E.; Gomes, C.L. Characterization of carvacrol beta-cyclodextrin inclusion complexes as delivery systems of antibacterial and antioxidant applications. LWT Food Sci. Technol. 2015, 60, 583–592. [Google Scholar] [CrossRef]
- Wang, T.; Li, B.; Si, H.; Lin, I.; Chen, L. Release characteristics and antibacterial activity of solid state eugenol/β-cyclodextrin inclusion complex. J. Incl. Phenom. Macrocycl. Chem. 2011, 71, 207–213. [Google Scholar] [CrossRef]
- Goñi, P.; López, P.; Sánchez, C.; Gómez-Lus, R.; Becerril, R.; Nerín, C. Antimicrobial activity in the vapour phase of a combination of cinnamon and clove essential oils. Food Chem. 2009, 116, 982–989. [Google Scholar] [CrossRef]

| Complexes | S0 (mmol L−1) | KC (L mol−1) | CE (%) | Molar Ratio |
|---|---|---|---|---|
| Carvacrol/β-CDs | 5.64 ± 0.12 | 1871 ± 143 | 105.6 ± 10.3 | 1:2 |
| Thymol/β-CDs | 5.77 ± 0.15 * | 1198 ± 115 | 69.3 ± 9.2 | 1:2 |
| Monoterpene | β-CD | EE (%) | PP (%) |
|---|---|---|---|
| Carvacrol | 11 mM | 45 ± 2.5 * | 84 ± 3.2 |
| Thymol | 11 mM | 47 ± 1.8 | 86 ± 3.7 |
| PLA Boxes with Different % of β-CD–Carvacrol | ||||
|---|---|---|---|---|
| Parameter | 0% | 1.50% | 2.50% | 5% |
| Young’s modulus (Mpa) | 2873 ± 176 | 2327 ± 170 * | 2259 ± 53 * | 1960 ± 110 * |
| Maximum stress (MPa) | 63.6 ± 4.5 | 49.9 ± 6.5 * | 51.3 ± 4.9 * | 47.5 ± 5.1 * |
| Breaking point (%) | 2.4 ± 0.4 | 2.7 ± 0.3 * | 2.9 ± 0.2 * | 3.2 ± 0.4 * |
| PLA Boxes with Different % of β-CD–Thymol | ||||
|---|---|---|---|---|
| Parameter | 0% | 1.50% | 2.50% | 5% |
| Young’s modulus (Mpa) | 2873 ± 176 | 2667 ± 161 * | 2382 ± 69 * | 2394 ± 118 * |
| Maximum stress (MPa) | 63.6 ± 4.5 | 57.9 ± 6.8 * | 53.2 ± 2.3 * | 55.1 ± 5.2 * |
| Breaking point (%) | 2.4 ± 0.4 | 2.8 ± 0.3 * | 2.9 ± 0.2 * | 3.1 ± 0.3 * |
| Parameter | Control * 0% | PLA–Thymol–β-CDs (wt%) | PLA–Carvacrol–β-CDs (wt%) | ||||
|---|---|---|---|---|---|---|---|
| 1.5% | 2.5% | 5.0% | 1.5% | 2.5% | 5.0% | ||
| Tg (°C) | 59 | 61 | 59 | 61 | 60 | 60 | 60 |
| Tcc (°C) | 102.7 | 103.8 | 105.4 | 105.0 | 106.5 | 107.7 | 105.9 |
| Tm (°C) | 168.5 | 168.5 | 168.5 | 168.8 | 167.9 | 168.8 | 169.1 |
| ΔHc Energy (J/g) | 36.09 | 33.08 | 30.61 | 29.03 | 36.42 | 32.09 | 36.83 |
| ΔHm Energy (J/g) | 45.63 | 44.09 | 37.44 | 35.65 | 44.72 | 37.54 | 42.95 |
| Type of Packaging | Encapsulation Concentration (% w/w) | Incubation Time | |
|---|---|---|---|
| 5 Days | 10 Days | ||
| PLA-control | 0.0% | 29.7 a | 69.0 |
| PLA–β-CD–thymol | 1.5% | 28.3 | 71.6 |
| 2.5% | 30.0 | 60.0 | |
| 5.0% | 3.3 * | 0.0 * | |
| PLA–β-CD–carvacrol | 1.5% | 29.7 | 65.3 |
| 2.5% | 0.0 * | 0.0 * | |
| 5.0% | 0.0 * | 0.0 * | |
© 2019 by the authors. Licensee MDPI, Basel, Switzerland. This article is an open access article distributed under the terms and conditions of the Creative Commons Attribution (CC BY) license (http://creativecommons.org/licenses/by/4.0/).
Share and Cite
Friné, V.-C.; Hector, A.-P.; Manuel, N.-D.S.; Estrella, N.-D.; Antonio, G.J. Development and Characterization of a Biodegradable PLA Food Packaging Hold Monoterpene–Cyclodextrin Complexes against Alternaria alternata. Polymers 2019, 11, 1720. https://doi.org/10.3390/polym11101720
Friné V-C, Hector A-P, Manuel N-DS, Estrella N-D, Antonio GJ. Development and Characterization of a Biodegradable PLA Food Packaging Hold Monoterpene–Cyclodextrin Complexes against Alternaria alternata. Polymers. 2019; 11(10):1720. https://doi.org/10.3390/polym11101720
Chicago/Turabian StyleFriné, Velázquez-Contreras, Acevedo-Parra Hector, Nuño-Donlucas Sergio Manuel, Núñez-Delicado Estrella, and Gabaldón José Antonio. 2019. "Development and Characterization of a Biodegradable PLA Food Packaging Hold Monoterpene–Cyclodextrin Complexes against Alternaria alternata" Polymers 11, no. 10: 1720. https://doi.org/10.3390/polym11101720






